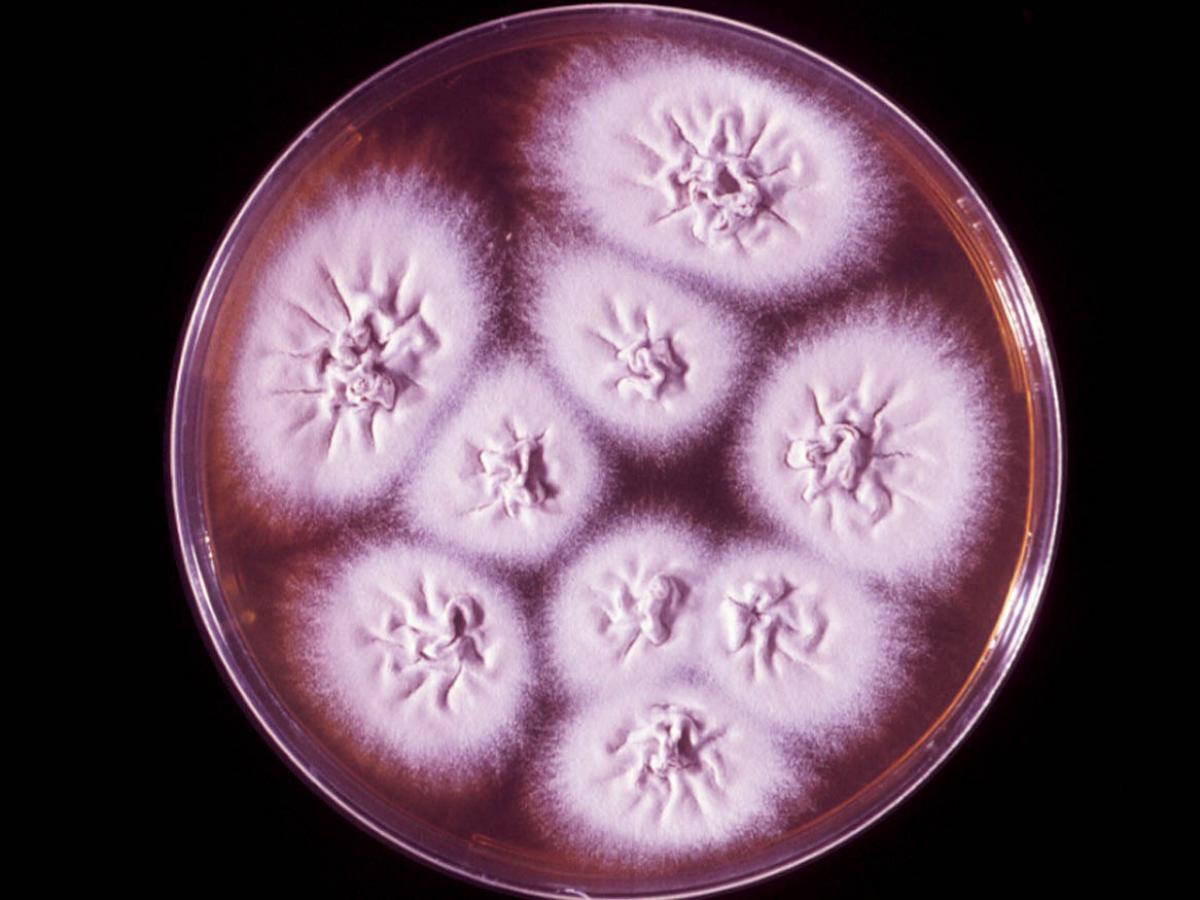
Culture

Status message
Correct! Excellent, you have really done well. Please find additional information below.
Unknown 70 = Trichophyton quinckeanum
Clinical presentation: Human (first below) and mouse (second below) favus showing thick saucer-shaped scutula caused by T. quinckeanum.


Culture: Cultures of T. quinckeanum are white, downy and dome-shaped when young; becoming heaped, folded and powdery due to the production of numerous microconidia with age. Reverse pigmentation is usually yellow-brown in colour.
Microscopy: Microscopic morphology of T. quinckeanum showing numerous microconidia, which are predominantly slender, clavate when young and borne laterally along the sides of the hyphae. With age the microconidia become broader and pyriform with some subspherical forms. Occasional to moderate numbers of smooth-walled, multiseptate, clavate macroconidia may be present in young cultures. RG-2 organism.

Comment: T. quinckeanum is a zoophilic dermatophyte and the cause of "mouse favus" seen on mice as thick saucer-shaped yellow crusted lesions called scutula. Infections in humans are usually inflammatory and sometimes produce scutula. Invaded hairs are rarely seen but they may show either ectothrix or endothrix infection. Infected human hairs do not fluoresce under Wood's ultra-violet light, but very occasional hairs from experimental lesions in guinea pigs may show a pale yellow fluorescence.
Distribution: Difficult to establish but probably world-wide. Often associated with mice plagues in the Australian Wheat Belt.
Key features: Culture characteristics, microscopic morphology, contact with mice, odour and rapid urease test.
About Trichophyton quinckeanum Back to virtual assessment